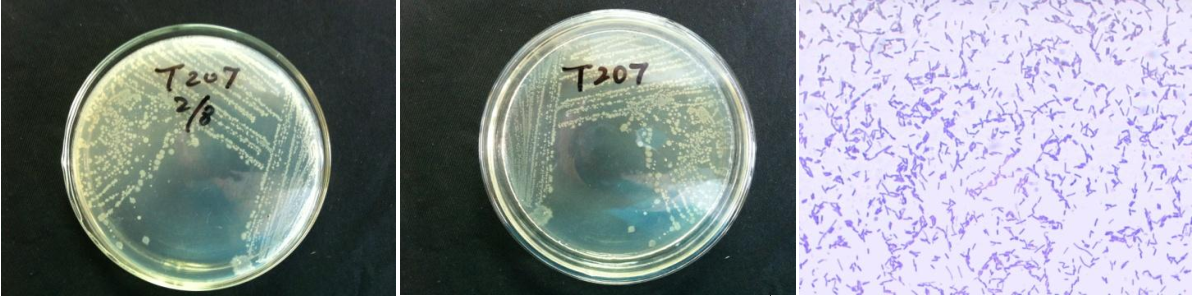

Loading...
| StrainNO | B407 |
| Classification | Solibacillus |
| 16s rDNA sequence | TGCTATACATGCAAGTCGAGCGGAAATTTTATTGGTGCTTGCACCTTTAAAATTTTAGCGGCGGACGGGTGAGTAACACGTGGGT AACCTACCTTATAGATTGGGATAACTCCGGGAAACCGGGGCTAATACCGAATAATACTTTTTAACACATGTTTGAAAGTTGAAAG ACGGCATCTCGCTGTCACTATAAGATGGACCCGCGGCGCATTAGCTAGTTGGTGAGGTAACGGCTCACCAAGGCAACGATGCGTA GCCGACCTGAGAGGGTGATCGGCCACACTGGGACTGAGACACGGCCCAGACTCCTACGGGAGGCAGCAGTAGGGAATCTTCCACA ATGGACGAAAGTCTGATGGAGCAACGCCGCGTGAGTGAAGAAGGATTTCGGTTCGTAAAACTCTGTTGCAAGGGAAGAACAAGTA GCGTAGTAACTGGCGCTACCTTGACGGTACCTTGTTAGAAAGCCACGGCTAACTACGTGCCAGCAGCCGCGGTAATACGTAGGTG GCAAGCGTTGTCCGGAATTATTGGGCGTAAAGCGCGCGCAGGTGGTTCCTTAAGTCTGATGTGAAAGCCCCCGGCTCAACCGGGG AGGGTCATTGGAAACTGGGGAACTTGAGTGCAGAAGAGGATAGTGGAATTCCAAGTGTAGCGGTGAAATGCGTAGAGATTTGGAG GAACACCAGTGGCGAAGGCGACTGTCTGGTCTGTAACTGACACTGAGGCGCGAAAGCGTGGGGAGCAAACAGGATTAGATACCCT GGTAGTCCACGCCGTAAACGATGAGTGCTAAGTGTTGGGGGGgTTTCCGCCCCTCAGTGCTGCAGCTAACGCATTAAGCACTCCG CCTGGGGAGTACGGTCGCAAGACTGAAACTCAAAGGAATTGACGGGGGCCCGCACAAGCGGTGGAGCATGTGGTTTAATTCGAAG CAACGCGAAGAACCTTACCAGGTCTTGACATCCCGGTGACCACTATGGAGACATAGTTTCCCCTTCGGGGGCAACGGTGACAGGT GGTGCATGGTTGTCGTCAGCTCGTGTCGTGAGATGTTGGGTTAAGTCCCGCAACGAGCGCAACCCTTATTCTTAGTTGCCATCAT TCAGTTGGGCACTCTAAGGAGACTGCCGGTGATAAACCGGAGGAAGGTGGGGATGACGTCAAATCATCATGCCCCTTATGACCTG GGCTACACACGTGCTACAATGGACGGTACAAACGGTTGCCAACCCGCGAGGGGGAGCTAATCCGATAAAACCGTTCTCAGTTCGG ATTGTAGGCTGCAACTCGCCTACATGAAGCCGGAATCGCTAGTAATCGCGGATCAGCATGCCGCGGTGAATACGTTCCCGGGCCT TGTACACACCGCCCGTCACACCACGAGAGTTTGTAACACCCGAAGTCGGTGAGGTAACCTTTGGAGC |
| Strain Morphology Photos | |
| Morphological Description | Colony round;light yellow;Flattened;edge neatly;slippy;sticky;translucent;Rod;no spore |